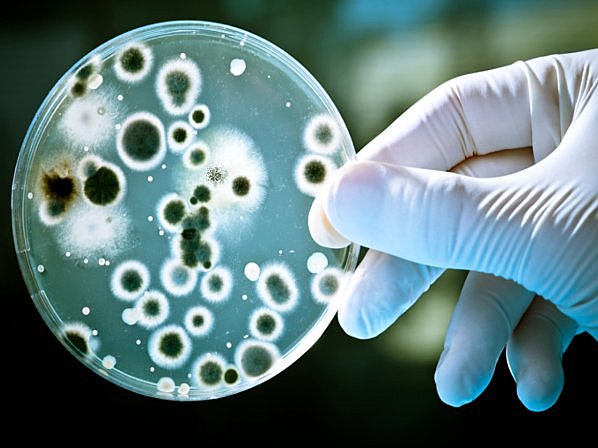
Los antibióticos

-
La ciencia en el Antiguo Egipto gozó de gran prestigio desde tiempos remotos. Es enormemente significativo el alto nivel que desarrolló esta civilización y la amplitud de conocimientos que llegaron a dominar. una de estas es la arquitectura egipcia, la cual desde tiempos remotos ha sido monumental, estos se ven reflejados en ej: «complejos de las pirámides», los templos y las tumbas (mastabas, speos, hipogeos y cenotafios), cuya grandiosidad dependía de la clase social del personaje a enterrar.
-
la creación de la pólvora la cual fue inventada en China cuando los ta oís tas intentaban crear una poción para la inmortalidad. Las fuerzas militares chinas usaban armas basadas en pólvora (cohetes, mosquetes, cañones) y explosivos (granadas y diferentes tipos de bombas) contra los mongoles cuando estos intentaban entrar en sus tierras en la frontera norte.
-
Para hablar de la historia de la ingeniería, debemos hacer un viaje ala prehistoria,donde se comenzaron a crear y a utilizar diferentes herramientas y técnicas para la supervivencia de la humanidad, como lanzas, flechas ,entre otras, las cuales fueron utilizada para defenderse, para conseguir comida y para construir sus lugares de habitad.
-
La invención de la balanza de brazos iguales se remonta a la época de los antiguos Egipcios,creció y dicho instrumento fue ampliamente difundido durante el imperio. Su sistema el siguiente: la romana de gancho tiene un astil pero de constitución asimétrica.
-
El Coliseo (Colosseum en latín), originalmente llamado Anfiteatro Flavio (Amphitheatrum Flavium), es un gran edificio situado en el centro de la ciudad de Roma, capital de Italia.
-
El científico inventó la denominada Pila de Volta, precursora de la batería eléctrica. Su trabajo resultó crucial para la historia de la ciencia, ya que, por primera vez, logró que se produjera un flujo estable de electricidad. La pila estaba hecha con discos de plata y discos de zinc, colocados de forma alterna y separados por discos de cartón embebidos en salmuera
-
Fue en el año 1752 cuando Franklin hizo su famoso experimento para demostrar que los rayos son una forma de electricidad.
-
creación y adaptación de la maquina propulsada a valor vapor para el trasporte e industrialización de los métodos de producción.
-
El primer telegrama de la historia se transmitió en 1844. Según los historiadores de la comunicación, el primer mensaje decía: «Qué nos ha deparado Dios». Sostienen que lo envió el inventor del telégrafo, Samuel Morse, quien también inventó el código de escritura
-
El 14 de enero de 1876, el inventor británico Alexander Graham Bell patentó el teléfono. El invento permitía, por primera vez, transmitir y recibir sonidos en tiempo real.
-
La creación de la primera lámpara eléctrica incandescente la creó Heinrich Göbel. El 27 de enero de 1880 le fue concedida la patente, con el número 223.898. ... Cabe recordar que el alemán, Heinrich Göbel ya había registrado su propia bombilla incandescente en 1855, mucho antes por tanto que Thomas A. Edison.
-
Creación e innovación de la televisión como fuente de entretenimiento e información en el trascurso de la edad contemporánea o actual.
-
En 1885 se crea el primer vehículo automóvil por motor de combustión interna con gasolina. El francés Nicolas-Joseph Cugnot (1725-1804) construyó un automóvil de vapor que circuló por París en 1769 y que perfeccionó en otros dos modelos.
-
Los hermanos Wright comenzaron a trabajar en la idea de construir aviones en 1899. Finalmente tuvieron éxito en volar el primer avión
-
desde este escocés descubrió la penicilina, un antibiótico que salvó la vida de millones de personas hasta nuestros días. A partir de aquí, comenzó una investigación que no ha parado, produciendo fármacos que ayudan a nuestro cuerpo a combatir enfermedades.
-
ingeniero alemán, diseño y fabricó la Z1, la que para muchos es la primera computadora programable de la historia. La Z1 era una calculadora mecánica binaria operada con electricidad y que ocupaba una mesa entera, bastante grande por cierto.
-
hace exactamente 50 años, la revista científica Nature publicó un texto en el que los científicos estadounidense James Watson y británico Francis Crick presentaban en sociedad su hallazgo de la estructura molecular en forma de doble hélice del ADN
-
fue una misión espacial tripulada de Estados Unidos cuyo objetivo fue lograr que un ser humano caminara en la superficie de la Luna.
-
Gracias al Internet tenemos al alcance de nuestras manos cualquier tipo de información que necesitamos o deseamos conocer. Este logro se atribuye a varias personas. Sin embargo, la idea inicial fue producto del trabajo del ingeniero y científico de computación Leonard Kleinrock.
-
También llamada la "Torre Califa" es el rascacielos más alto de mundo, cuenta con una altura aproximada de 828 metros y se encuentra ubicada en Dubái. Sin duda alguna, la construcción de este rascacielos ha sido uno de los más grandes retos de la ingeniería y su resultado exitoso ha sido realmente impresionante. La construcción de esta infraestructura inició el 21 de septiembre del 2004 y finalizó el 4 de enero de 2010, día en que fue inaugurada.
-
Los coches sin conductor podrían tardar todavía algunos años para hacerse realidad, pero en 2018 el nivel de automatización de los coches se acelerará rápidamente.